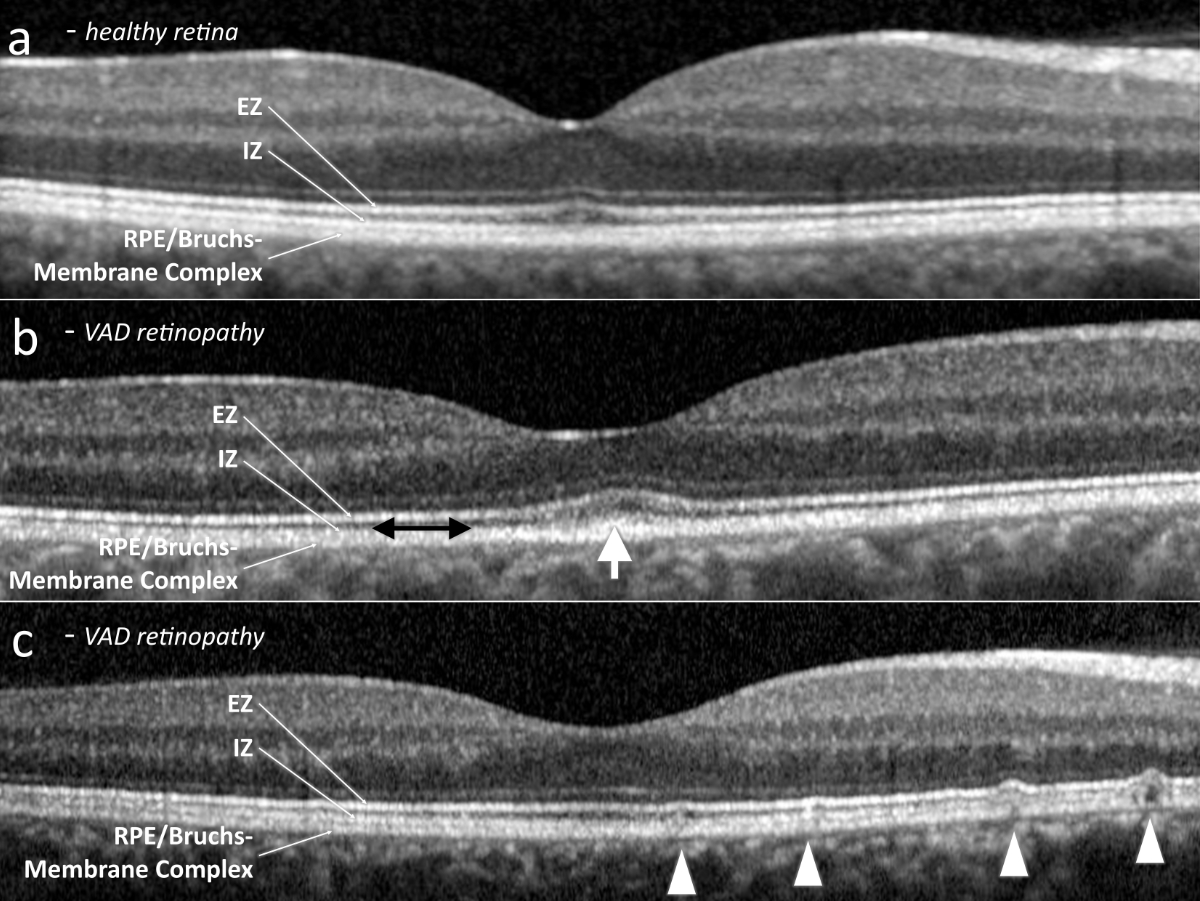

DOI: https://doi.org/https://doi.org/10.57187/smw.2023.40097
Humans obtain vitamin A as the preformed vitamin retinol or as its provitamins, the carotenoids. All are fat soluble. In the small intestine, dietary retinyl esters are hydrolysed by pancreatic enzymes to unesterified retinol [1]. Retinol, in addition to dietary carotenoids, is then absorbed into the enterocytes. Retinol is subsequently either re-esterified and joins with carotenoids to form chylomicrons, which enter the lymphatic system, or enters directly into the portal blood system via a lipid transporter. The liver stores vitamin A and normally contains a reserve sufficient for six months to two years [1–3]. Vitamin A is crucial for the physiological function of photoreceptors [4–6].
In developed countries, vitamin A deficiency due to malnutrition is rare. The World Health Organization global database on vitamin A deficiency excludes countries with a per capita gross domestic product of >15,000 USD because their levels of vitamin A deficiency are assumed to be too low to be of significance for public health. However, vitamin A deficiency can arise due to malabsorption secondary to bowel shortening, for example in cases of bariatric surgery; as a side effect of medication [7–12]; or as a result of disease, such as cystic fibrosis [9]. Micronutrient deficiency is a well-known problem after bariatric surgery and can occur even with preventive supplemental intake [10, 13]. Deficiencies tend to increase over time as storage is depleted. In contrast to vitamin D or calcium levels, vitamin A levels are not routinely monitored after bariatric surgery, permitting the development of clinical manifestations of vitamin A deficiency, such as night blindness or xerophthalmia. A similar issue occurs with medication that increases fatty stools, such as somatostatin analogues, which can lead to deficiency in all fat-soluble vitamins, including vitamin A [8].
The typical manifestation of vitamin A deficiency retinopathy is night blindness, which is mainly caused by an elevated rod threshold due to reduced rhodopsin levels. This results in reduced dark adaptation [14]. In milder cases, dark adaptation is achieved but as a slower rate [14, 15]. Cones are affected only in very severe and long-lasting vitamin A deficiency [14, 15]. Changes in electrophysiological examinations were described by Arden in 1964 [16]. He noted a diminished electroretinogram response and an abnormal electrooculogram in a patient with vitamin A deficiency who was experiencing night blindness. More recent reports describe the typical electroretinogram findings as reduced or absent rod responses in the presence of preserved light-adapted single flash and reduced 30 Hz flicker responses [17, 18]. Results of retinal imaging are variable, likely depending on the severity and duration of the vitamin A deficiency. Fundus autofluorescence typically indicates various degrees of speckled patches of hypoautofluorescence [19]. Optical coherence tomography can detect abnormal outer retinal foveal hyperreflectivity, disappearance of the interdigitation zone, disruption of the ellipsoid zone, white spots resembling subretinal drusenoid deposits typical of age-related macular degeneration, and thinning of the outer nuclear layer [19–25]. These findings are not specific to vitamin A deficiency retinopathy and exhibit high interindividual variability. Due to the rarity of vitamin A deficiency retinopathy, the fundus autofluorescence and optical coherence tomography findings may be easily missed or attributed to a different retinal pathology.
In this case series, we consider five patients who developed likely iatrogenic symptomatic vitamin A deficiency retinopathy, either following surgical intervention or as a side effect of medication.
For this single-centre retrospective case study the electronic health records of the Department of Ophthalmology at the University Hospital of Zurich were used as a database. All authors have access to these electronic health records by virtue of their employment at the Department of Ophthalmology. The clinic information system used at the department (KISIM, CISTEC AG, Zurich, Switzerland) has an integrated algorithm for keyword searches, operable only by designated staff after approval from the hospital’s data governance board. For this study, only records of patients who had previously provided informed general consent for further use of their data for research purposes were searched. The records between January 2012 and April 2022 were electronically screened for keywords including vitamin A deficiency as well as bariatric surgery or variations thereof (see figure 1 for detailed list). The search was performed on the free texts of the record entries in the designated field for diagnosis using OR (not exclusive) logic. This search strategy results in positive hits in case of negation, such as “no vitamin A deficiency”, but misses cases with misspelled diagnoses. Only the first positive hit per patient was returned to avoid duplication. The resulting records of this search were then manually screened by a physician for a true diagnosis of vitamin A deficiency retinopathy, especially by abnormalities in the outer retinal layers as detected by retinal imaging and abnormal electrophysiologic examination. Only cases with laboratory-confirmed vitamin A levels below normal (lower limit of the normal range is 0.30 mg/l at our laboratory) and history of a medical intervention likely causing or related to vitamin A malabsorption were included. Symptoms, duration of symptoms, visual acuity, and vitamin A levels were recorded. Results of optical coherence tomography, fundus autofluorescence, electroretinograms, and dark adaptation tests were reviewed if available. Electroretinograms were performed according to the International Society for Electrophysiology of Vision (ISCEV) guidelines valid at the respective time [26, 27]. Further relevant medical history, especially history of bariatric surgery, liver disease, or specific medication known for hindering fat-soluble vitamin uptake, was noted, including the time between any intervention and diagnosis of vitamin A deficiency retinopathy.
For the database search, KISIM (CISTEC AG, Zurich, Switzerland) has been used.
Statistics were performed using IBM SPSS Statistics (Version 26.0. Armonk, NY: IBM Corp). Median and range were calculated for age, duration of symptoms prior to diagnosis, visual acuity, and vitamin A levels (as data could not be assumed to be normally distributed).

Figure 1Study selection process flow chart.
The study was conducted in accordance with the Declaration of Helsinki and approved by the Cantonal Ethics Committee of Zurich (Basec no. PB_2016-00264, initially approved January 2016, extension approved October 2018).
The initial electronic database search found 116 possible patients. After manual verification of these electronic health records, five patients had laboratory-confirmed vitamin A deficiency retinopathy and history of a medical intervention or medication likely causing or related to a vitamin A malabsorption (figure 1, tables 1 and 2). Median age was 44.7 years (range 22.2–88.9 years). All patients were female. The presenting symptom in all patients was night blindness, in one case combined with tunnel vision. Median duration of symptoms prior to diagnosis was 14 months (range 1–16 months). Median visual acuity was 1.0 (range 0.5–1.0, Snellen, decimal). Median vitamin A level was 0.07 mg/l (range 0.06–0.24 mg/l); the local normal range is 0.30–0.70 mg/l.
Table 1
Demographic data.
| Patients included (n) | 5 | |
| Gender | female/male | 5/0 |
| Age (years) | median (range) | 44.7 (22.1–88.9) |
| Visual acuity (Snellen, decimal) | median (range) in right/left eye | 1.0 (0.8–1.0) / 1.0 (0.5–1.0) |
| Duration of symptoms until diagnosis (months) | median (range) | 14 (1–16) |
Table 2Overview of all cases.
| ID/g | Age (years) | Symptoms | Duration (years) | VA right | VA left | Vit A level (mg/l) | ERG abnormalities | DA | OCT | FAF | Systemic associated disease |
| 1/f | 88.9 | Night blindness | 1.4 | 1.0 | 0.5 | 0.08 | Non-recordable rod responses. Reduced and delayed mixed rod-cone a- and b-waves with pseudo-negative configuration. | n/a | Thinned ONL, atrophic EZ, subretinal drusenoid deposits. | speckled | NET, small bowel resection 10 years prior, octreotide treatment for 8 years. |
| 2/f | 51.7 | Night blindness | 1.4 | 1.0 | 1.0 | 0.06 | Reduced mixed rod-cone a-wave amplitudes | Slowed and reduced | Slightly reduced interdigitation zone | speckled | Gastric bypass surgery 9 years prior |
| 3/f | 44.7 | Night blindness | 0.8 | 1.0 | 1.0 | 0.07 | Abnormal OP | Slowed and reduced | Reduced interdigitation zone, foveal hyperreflective outer retinal lazers | n/a | Gastric bypass surgery 7 years prior |
| 4/f | 40.7 | Night blindnestunnel vision | 1.2 | 0.8 | 0.8 | 0.24 | Delayed mixed rod-cone a- and b-waves, asymmetric abnormal OP | n/a | Subretinal drusenoid deposits | speckled | Gastric bypass surgery 3 years prior |
| 5/f | 22.2 | Night blindness | 0.1 | 1.0 | 1.0 | 0.06 | Non-recordable rod responses. Reduced mixed rod-cone a- and b-wave amplitudes with supernormal b-wave peak time (comparable to single flash cone b-wave peak time), abnormal OP | Severely reduced | Missing interdigitation zone | speckled | Cystic fibrosis; ileum and jejunum resection 12 and 4 years prior, severe hepatopathy; history of lung transplantation |
DA: dark adaptation, ERG: electroretinogram, EZ: ellipsoid zone, f: female, FAF: fundusautofluorescence, g: gender, ID: identification number, n/a: not applicable, NET: neuroendocrine tumor, OCT: optical coherence tomography, ONL: outer nuclear layer, OP: oscillatory potentials, VA: visual acuity.
All patients had visible alterations of the outer retinal layers shown by optical coherence tomography (figure 2). These ranged from minimal irregularity to a complete absence of the interdigitation zone or an altered ellipsoid zone. Patients also varied in the presence of subretinal drusenoid deposits. Fundus autofluorescence showed varying degrees of speckled patches of hypofluorescence in four patients (the remaining patient did not undergo fundus autofluorescence imaging) (figure 3). Electroretinogram findings varied widely from abnormal oscillatory potentials to reduced or delayed mixed rod–cone a- and/or b-waves to non-recordable rod responses (for details see table 2). Three patients had dark adaptation tested, and all findings were pathological (figure 4). Two patients displayed abnormally slowed dark adaptation with reduced sensitivity throughout the 30-minute testing period, while the other patient exhibited no reproducible change in sensitivity over the test duration. In terms of associated systemic history, three patients underwent bariatric surgery (all gastric bypasses) three, seven, and nine years prior to diagnosis of vitamin A deficiency retinopathy, respectively. One patient had a small bowel resection 10 years prior and had been on octreotide treatment for eight years due to a neuroendocrine tumour. Another patient had a history of cystic fibrosis; ileum and jejunum resections 12 and four years prior, respectively; lung transplantation; and severe hepatopathy of mixed origin, possibly secondary to polymedication.
Figure 2Subfoveal optical coherence tomography. (a) Exemplary healthy retina. (b) Vitamin A deficiency retinopathy, presenting abnormal outer retinal foveal hyperreflectivity (white arrow) and a reduced interdigitation zone (black double arrow). (c) Vitamin A deficiency retinopathy, revealing subretinal drusenoid deposits (arrow heads). EZ: ellipsoid zone; ONL: outer nuclear layer; RPE: retinal pigment epithelium.

Figure 3Fundus autofluorescence. (a) Exemplary healthy retina. (b) Vitamin A deficiency retinopathy, presenting speckled hypoautofluorescent patches at the posterior pole.

Figure 4Dark adaptation of patients 2, 3 and 5. Patients 2 (square box line) and 3 (dashed line) displayed abnormally slow dark adaptation with reduced sensitivity throughout the 30-minute testing period. Patient 5 (dotted line) exhibited no reproducible increase in sensitivity over the test duration. (Note: the first five minutes correspond to the pre-measurement bleaching period.)
An 87-year-old female (patient 1, table 2) presented at the emergency clinic of the Department of Ophthalmology after suffering bilateral visual disturbances for one to two months. She had a history of breast cancer, which was diagnosed the same year and treated surgically, followed by ongoing treatment with tamoxifen. She had a further history of a neuroendocrine tumour of the small bowel, which had been diagnosed ten years prior and had been treated surgically with a small bowel resection and adjuvant chemotherapy, and she was receiving ongoing treatment with octreotide (Sandostatin®). Ocular findings in both eyes included non-exudative age-related macular degeneration and pseudoexfoliation glaucoma. A trabeculectomy had previously been performed in the left eye. Since this operation, the pupil had not been reactive to mydriatic eye drops. Visual acuity was 0.6 in the right and 0.4 in the left eye. Slit-lamp examination showed a cataract in the right eye and pseudophakia with posterior capsule opacification in the left eye. Fundus biomicroscopy revealed numerous round, yellow-white lesions along the temporal arcades at the posterior pole and nasally to the optic nerve in both eyes. These lesions resembled subretinal drusenoid deposits on optical coherence tomography (figure 5).
We arranged further investigations into the patient’s symptoms in our general ophthalmology clinic; however, she decided to return to her ophthalmologist in private practice and cancelled the hospital appointments. Twelve months later, she was referred to our clinic for exacerbation of her visual disturbances, notably increasing night blindness, which she initially described as “everything gets darker and darker”. Visual acuity was 0.6 in the right and 0.5 in the left eye. Again, optical coherence tomography showed numerous subretinal drusenoid deposits resembling lesions (figure 5). Additionally, there was a noticeable thinning of the outer nuclear layer compared to one year prior, as well as marked alterations of the ellipsoid zone and the interdigitation zone. Fundus autofluorescence presented bilateral speckled patches of hypoautofluorescence and some hyperautofluorescence (figure 5). Electrophysiological examination showed non-recordable rod responses, pseudo-negative mixed rod–cone electroretinogram configurations [28], and reduced 30 Hz flicker responses (figure 6). Dark adaptation testing was not performed. Blood tests revealed a vitamin A level of 0.08 mg/l (lower limit of local normal range 0.30 mg/l). The patient was also tested for the presence of anti-recoverin, anti-enolase, and anti-retina IgGAM antibodies, none of which were detectable. Oral supplementation of vitamin A (30,000 IE daily) was initiated immediately. The patient did not notice any improvement within the first two weeks. However, after two months she reported a marked improvement of her symptoms. At that time, vitamin A levels were within normal limits (0.43 mg/l). Optical coherence tomography showed milder alterations of the ellipsoid zone and the interdigitation zone and fewer subretinal drusenoid deposits, as well as a slight increase in the thickness of the outer nuclear layer. Fundus autofluorescence revealed fewer speckled patches. An electroretinogram indicated noticeably improved scotopic responses, including clearly measurable rod responses. A pseudo-negative configuration was no longer present. Due to the postoperative anisocoria described above, with a non-dilating left pupil, the results of both electroretinogram examinations were asymmetric (right eye > left eye).

Figure 5Multimodal imaging of patient 1. (a) Fundus photography at time of diagnosis of vitamin A deficiency. Note the numerous round, yellow-white lesions at the posterior pole in both eyes. (b) Fundus autofluorescence at baseline with speckled patches of hypoautofluorescence and some hyperautofluorescence and after vitamin A supplementation, showing a reduction of the speckled patches. (c) Optical coherence tomography one year before diagnosis of vitamin A deficiency, at diagnosis of vitamin A deficiency, and after vitamin A supplementation. Note the thinning of the outer nuclear layer before vitamin A deficiency diagnosis and partial recovery after supplementation. Additionally, an altered ellipsoid zone and interdigitation zone are visible, in addition to subretinal drusenoid deposits, also demonstrating partial recovery after supplementation.EZ: Ellipsoid zone; ONL: Outer nuclear layer.

Figure 6Electrophysiological examination of patient 1 at baseline and after vitamin A supplementation. Baseline shows non-recordable rod responses, pseudo-negative mixed rod–cone electroretinogram configurations, and reduced 30 Hz flicker responses. After six weeks of vitamin A supplementation, the electroretinogram showed noticeably improved scotopic responses, including clearly detectable rod responses (dark-adapted 0.01). A pseudo-negative configuration was no longer present. Note: The results of both electroretinogram examinations were asymmetric (right eye > left eye) due to a non-dilating left pupil.ERG: Electroretinogram; OP: Oscillatory potentials.
In countries where malnutrition is uncommon, vitamin A deficiency is a rare occurrence; therefore, the time between first symptoms and diagnosis can be prolonged. Vitamin A deficiency retinopathy is generally a reversible disease but can progress to permanent blindness if left untreated [4, 20, 29–33]. All our patients presented with night blindness, reinforcing the importance of considering a thorough history of a patient’s visual symptoms, as patients will note various visual issues but may not perceive them as night blindness. In cases of vitamin A deficiency, rods are known to be affected before cones, likely due to the provision of 11-cis-retinal through the Müller cells [6, 34]. Furthermore, it seems that not all types of cones are affected simultaneously, with S-cones being affected first [34]. Publications documenting electroretinograms in patients with vitamin A deficiency have described an earlier and more extensive rod involvement, and cone electroretinograms can indicate a reduced amplitude or longer latency [35–37]. Full-field electroretinograms showed diverse abnormalities of variable severity in all five patients in accordance with the previous publications discussed above. In our cohort, the three patients who were tested for dark adaptation all showed pathological findings, fitting their symptoms.
Optical coherence tomography and fundus autofluorescence findings agree with previously published results [19–23, 32]. Our cases show changes of differing severity at the level of the ellipsoid zone and interdigitation zone, in some cases combined with alterations of the retinal pigment epithelium and subretinal drusenoid deposits. In one case, we observed a thinning of the outer nuclear layer. Subtle changes may easily be missed or dismissed as image noise; others can be hard to separate from changes due to age-related macular degeneration, which is (depending on age) a far more common disease. This again emphasizes the importance of careful examination of medical history, as age-related macular degeneration would more likely be associated with decreased reading ability or central scotoma and less likely with night blindness. In uncertain cases, a full-field electroretinogram may help to distinguish between age-related macular degeneration and vitamin A deficiency retinopathy. Subretinal drusenoid deposits in age-related macular degeneration can have the same appearance as in vitamin A deficiency retinopathy but would not lead to an altered full-field electroretinogram with non-recordable rod responses [38].
In all our cases, the surgical interventions or medical treatments had taken place several years prior to the first symptoms of vitamin A deficiency retinopathy, which is in accordance with reports of other micronutrient deficiencies [7, 12, 13, 39]. Due to this time lag, a patient often might not connect their vision problems to their earlier medical history and might not spontaneously inform their ophthalmologist about these interventions or medication intake. In cases of night blindness, doctors, especially ophthalmologists, should ask specifically about a history of bariatric or other gastrointestinal surgery and for a complete list of the patient’s current medications. In cases of night blindness with possible vitamin A deficiency due to a patient’s medical history or suggestive imaging findings, vitamin A levels should be measured.
The main limitation of our study is the small and mixed cohort. Further, our database search was limited to patients who had already signed a general consent form permitting the use of their health-related data for research purposes prior to the search. The number of patients with vitamin A deficiency retinopathy treated at the department who did not sign the general consent form is unknown. Generalisation of the findings is therefore limited. Further, vitamin A levels are not routinely measured in ophthalmologic workups in developed countries, and retinopathies might be misdiagnosed. Therefore, there is a possibility of underreporting vitamin A deficiency retinopathy.
Further imaging data can be found in the supplementary material. More detailed information cannot be released to protect patient confidentiality.
This study did not receive any direct external funding. Personal research funding of the authors within the last 36 months: James V. M. Hanson has received research funding from the Bruppacher Stiftung and Velux Stiftung. Daniel Barthelmes has received research grants from Novartis (Schweiz) AG. Sandrine A. Zweifel has received research grants from Bayer (Schweiz) AG and Novartis (Schweiz) AG.
All authors have completed and submitted the International Committee of Medical Journal Editors form for disclosure of potential conflicts of interest. No potential conflict of interest related to the content of this manuscript was disclosed.
1. Harrison EH. Mechanisms involved in the intestinal absorption of dietary vitamin A and provitamin A carotenoids. Biochim Biophys Acta. 2012 Jan;1821(1):70–7. 10.1016/j.bbalip.2011.06.002
2. Haaker MW, Vaandrager AB, Helms JB. Retinoids in health and disease: A role for hepatic stellate cells in affecting retinoid levels. Biochim Biophys Acta Mol Cell Biol Lipids. 2020 Jun;1865(6):158674. 10.1016/j.bbalip.2020.158674
3. O’Byrne SM, Blaner WS. Retinol and retinyl esters: biochemistry and physiology. J Lipid Res. 2013 Jul;54(7):1731–43. 10.1194/jlr.R037648
4. Sajovic J, Meglič A, Glavač D, Markelj Š, Hawlina M, Fakin A. The Role of Vitamin A in Retinal Diseases. Int J Mol Sci. 2022 Jan;23(3):1014. 10.3390/ijms23031014
5. Zhong M, Kawaguchi R, Kassai M, Sun H. Retina, retinol, retinal and the natural history of vitamin A as a light sensor. Nutrients. 2012 Dec;4(12):2069–96. 10.3390/nu4122069
6. Saari JC. Vitamin A metabolism in rod and cone visual cycles. Annu Rev Nutr. 2012 Aug;32(1):125–45. 10.1146/annurev-nutr-071811-150748
7. Jalilvand A, Blaszczak A, Needleman B, Hsueh W, Noria S. Vitamin A Deficiency in Patients Undergoing Sleeve Gastrectomy and Gastric Bypass: A 2-Year, Single-Center Review. J Laparoendosc Adv Surg Tech A. 2020 Jan;30(1):20–30. 10.1089/lap.2019.0627
8. Fiebrich HB, Van Den Berg G, Kema IP, Links TP, Kleibeuker JH, Van Beek AP, et al. Deficiencies in fat-soluble vitamins in long-term users of somatostatin analogue. Aliment Pharmacol Ther. 2010 Dec;32(11-12):1398–404. 10.1111/j.1365-2036.2010.04479.x
9. Norsa L, Zazzeron L, Cuomo M, Claut L, Bulfamante AM, Biffi A, et al. Night Blindness in Cystic Fibrosis: The Key Role of Vitamin A in the Digestive System. Nutrients. 2019 Aug;11(8):1876. 10.3390/nu11081876
10. Slater GH, Ren CJ, Siegel N, Williams T, Barr D, Wolfe B, et al. Serum fat-soluble vitamin deficiency and abnormal calcium metabolism after malabsorptive bariatric surgery. J Gastrointest Surg. 2004 Jan;8(1):48–55. 10.1016/j.gassur.2003.09.020
11. Hari T, Elsherbiny S. Bariatric surgery-what the ophthalmologist needs to know. Eye (Lond). 2022 Jun;36(6):1147–53. 10.1038/s41433-021-01811-8
12. Tiang, S. and R. Warne, Nyctalopia: the sequelae of hypovitaminosis A. BMJ Case Rep, 2010. 2010. 10.1136/bcr.05.2010.2965
13. Gasteyger C, Suter M, Gaillard RC, Giusti V. Nutritional deficiencies after Roux-en-Y gastric bypass for morbid obesity often cannot be prevented by standard multivitamin supplementation. Am J Clin Nutr. 2008 May;87(5):1128–33. 10.1093/ajcn/87.5.1128
14. Lamb TD, Pugh EN Jr. Dark adaptation and the retinoid cycle of vision. Prog Retin Eye Res. 2004 May;23(3):307–80. 10.1016/j.preteyeres.2004.03.001
15. Carney EA, Russell RM. Correlation of dark adaptation test results with serum vitamin A levels in diseased adults. J Nutr. 1980 Mar;110(3):552–7. 10.1093/jn/110.3.552
16. Arden GB, Kolb H. Electrophysiological investigations in retinal metabolic disease: their range and application. Exp Eye Res. 1964 Dec;3(4):334–47. 10.1016/S0014-4835(64)80041-5
17. Kakiuchi D, Uehara T, Shiotani M, Nakano-Ito K, Suganuma A, Aoki T, et al. Oscillatory potentials in electroretinogram as an early marker of visual abnormalities in vitamin A deficiency. Mol Med Rep. 2015 Feb;11(2):995–1003. 10.3892/mmr.2014.2852
18. O’Neill EK, Smith R. Visual electrophysiology in the assessment of toxicity and deficiency states affecting the visual system. Eye (Lond). 2021 Sep;35(9):2344–53. 10.1038/s41433-021-01663-2
19. Breazzano, M.P., et al., Vitamin A deficiency and the retinal "double carrot" sign with optical coherence tomography. Eye (Lond), 2022.
20. Saenz-de-Viteri M, Sádaba LM. Optical Coherence Tomography Assessment Before and After Vitamin Supplementation in a Patient With Vitamin A Deficiency: A Case Report and Literature Review. Medicine (Baltimore). 2016 Feb;95(6):e2680. 10.1097/MD.0000000000002680
21. Jevnikar K, Šuštar M, Kozjek NR, Štrucl AM, Markelj Š, Hawlina M, et al. Disruption of the outer segments of the photoreceptors on optical coherence tomography as a feature of vitamin A deficiency. Retin Cases Brief Rep. 2022 Sep;16(5):658–62. 10.1097/ICB.0000000000001060
22. Berkenstock MK, Castoro CJ, Carey AR. Outer retina changes on optical coherence tomography in vitamin A deficiency. Int J Retina Vitreous. 2020 Jun;6(1):23. 10.1186/s40942-020-00224-1
23. Zatreanu L. Macular thickness analysis and resolution of subretinal drusenoid deposits with optical coherence tomography in vitamin A deficiency-related retinopathy. Am J Ophthalmol Case Rep. 2021 Feb;21:101023. 10.1016/j.ajoc.2021.101023
24. Zweifel SA, Spaide RF, Curcio CA, Malek G, Imamura Y. Reticular pseudodrusen are subretinal drusenoid deposits. Ophthalmology. 2010 Feb;117(2):303–12.e1. 10.1016/j.ophtha.2009.07.014
25. Zweifel SA, Imamura Y, Spaide TC, Fujiwara T, Spaide RF. Prevalence and significance of subretinal drusenoid deposits (reticular pseudodrusen) in age-related macular degeneration. Ophthalmology. 2010 Sep;117(9):1775–81. 10.1016/j.ophtha.2010.01.027
26. Robson AG, Nilsson J, Li S, Jalali S, Fulton AB, Tormene AP, et al. ISCEV guide to visual electrodiagnostic procedures. Doc Ophthalmol. 2018 Feb;136(1):1–26. 10.1007/s10633-017-9621-y
27. Robson AG, Frishman LJ, Grigg J, Hamilton R, Jeffrey BG, Kondo M, et al. ISCEV Standard for full-field clinical electroretinography (2022 update). Doc Ophthalmol. 2022 Jun;144(3):165–77. 10.1007/s10633-022-09872-0
28. Holder GE, Mahroo O. Electronegative ERG or pseudo-negative ERG? Doc Ophthalmol. 2022 Dec;145(3):283–6. 10.1007/s10633-022-09881-z
29. McBain VA, Egan CA, Pieris SJ, Supramaniam G, Webster AR, Bird AC, et al. Functional observations in vitamin A deficiency: diagnosis and time course of recovery. Eye (Lond). 2007 Mar;21(3):367–76. 10.1038/sj.eye.6702212
30. Sommer A. Xerophthalmia, keratomalacia and nutritional blindness. Int Ophthalmol. 1990 May;14(3):195–9. 10.1007/BF00158318
31. Spits Y, De Laey JJ, Leroy BP. Rapid recovery of night blindness due to obesity surgery after vitamin A repletion therapy. Br J Ophthalmol. 2004 Apr;88(4):583–5. 10.1136/bjo.2003.022459
32. Choi S, Pandit S, Patil SA, Brodie SE. Documentation of recovery from vitamin A deficiency-related retinopathy via multimodal imaging and electroretinogram testing. Doc Ophthalmol. 2022 Oct;145(2):157–62. 10.1007/s10633-022-09888-6
33. Courtright P, Hutchinson AK, Lewallen S. Visual impairment in children in middle- and lower-income countries. Arch Dis Child. 2011 Dec;96(12):1129–34. 10.1136/archdischild-2011-300093
34. Miyazono S, Shimauchi-Matsukawa Y, Tachibanaki S, Kawamura S. Highly efficient retinal metabolism in cones. Proc Natl Acad Sci USA. 2008 Oct;105(41):16051–6. 10.1073/pnas.0806593105
35. Poornachandra B, Jayadev C, Sharief S, Shetty R. Serial ERG monitoring of response to therapy in vitamin A deficiency related night blindness. BMJ Case Rep. 2022 Mar;15(3):e247856. 10.1136/bcr-2021-247856
36. Perlman I, Barzilai D, Haim T, Schramek A. Night vision in a case of vitamin A deficiency due to malabsorption. Br J Ophthalmol. 1983 Jan;67(1):37–42. 10.1136/bjo.67.1.37
37. Scholl HP, Zrenner E. Electrophysiology in the investigation of acquired retinal disorders. Surv Ophthalmol. 2000;45(1):29–47. 10.1016/S0039-6257(00)00125-9
38. Aleman TS, Garrity ST, Brucker AJ. Retinal structure in vitamin A deficiency as explored with multimodal imaging. Doc Ophthalmol. 2013 Dec;127(3):239–43. 10.1007/s10633-013-9403-0
39. Lee WB, Hamilton SM, Harris JP, Schwab IR. Ocular complications of hypovitaminosis a after bariatric surgery. Ophthalmology. 2005 Jun;112(6):1031–4. 10.1016/j.ophtha.2004.12.045
More optical coherence tomography and fundus autofluorescence images are available below.

Figure S1Subfoveal optical coherence tomography scans of patients 2–5. (a) Patient 2 with slightly reduced interdigitation zone. (b) Patient 3 with abnormal foveal outer retinal hyperreflectivity and reduced interdigitation zone. (c) Patient 4 revealing drusenoid deposits. (d) Patient 5 with reduced interdigitation zone.

Figure S2Fundus autofluorescence of patients (a) 2, (b) 3 and (c) 5. All presenting speckled hypoautofluorescent patches at the posterior pole.